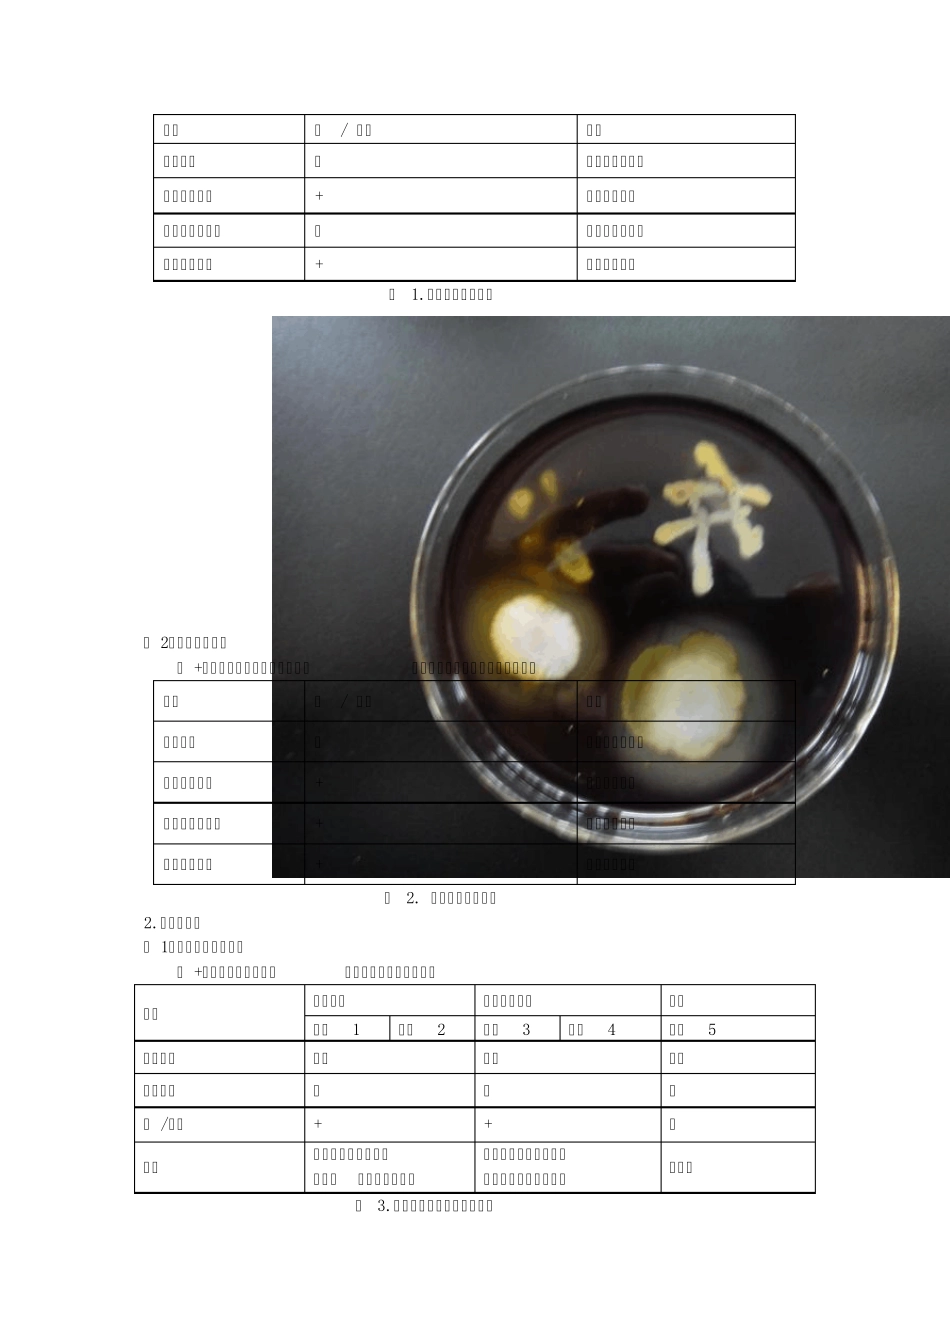
微生物鉴定中常用的生理生化试验_第3页

微生物鉴定中常用的生理生化试验 09级生科3班 李雪彤(200900140061) 同组者:刘雯雯、娄峰、潘红芳、朴薇 一、实验目的 1
证明不同微生物对各种有极大分子物质的水解能力不同,从而说明不同微生物有着不同的酶系统
掌握微生物大分子物质水解实验的原理和方法
了解糖发酵的原理和在肠细菌鉴定中重要作用
掌握通过糖发酵鉴别不同微生物的方法
了解IMViC 的原理
二、实验原理 由于各种微生物具有不同的酶系统,所以它们能利用的底物不同,或虽利用相同的底物但产生的代谢产物却不同,因此可以利用各种生理生化反应来鉴别不同的细菌,尤其是在肠杆菌科细菌的鉴定中,生理生化试验占有重要的地位
具体的原理如下: 1
淀粉水解试验:在淀粉固体培养基上接种四种细菌(枯草芽孢杆菌、大肠杆菌、金黄色葡萄球菌、铜绿假单胞菌),培养两天以后,再往培养基中加碘液染色,若该细菌能分泌胞外淀粉酶,则能利用其周围的淀粉,淡然在染色后,其菌落周围不呈蓝色,而是无色透明圈
糖发酵试验:不同的细菌分解糖的能力不同,有些细菌能利用糖发酵产酸和产气,有些则不能
酸在加入溴甲酚指示剂后会使溶液呈黄色,且德汉氏小管中会收集到一部分气体
若细菌不能使糖产酸产气,则最后溶液为指示剂的紫色,且德汉氏小管中无气体
IMVC 实验主要用于快速鉴别大肠杆菌和产气肠杆菌
( 1)吲哚试验:在蛋白胨培养基中,若细菌能产生色氨酸酶,则可将蛋白胨中的色氨酸分解为丙酮酸和吲哚,吲哚与对二甲基苯甲醛反应生成玫瑰色的玫瑰吲哚
本次不做该试验
( 2)甲基红试验(MR):某些细菌在糖代谢过程中分解葡萄糖生成丙酮酸,后者进而被分解产生甲酸,乙酸和乳酸等多种有机酸,是培养液PH 值降至4
2 以下,加入甲基红后溶液呈红色
三、实验材料 1
菌种 大肠杆菌(Escherichia coli),金黄色葡萄球(Sta